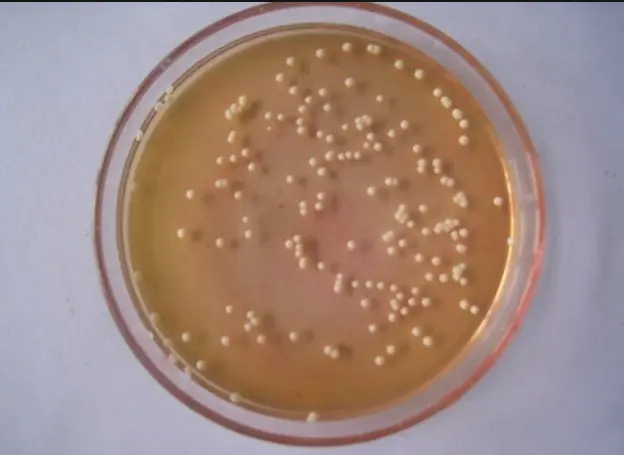
平板培养基

如何做好培养基的灌装16步。
发布时间:2025-07-11 浏览次数:3015
文章来源:制药人职场加油站 公众号
得到在无菌生产过程中是否会发生容器、未分装产品及灌装产品、未分装产品及灌装产品被微生物侵入的直观信息,这一工艺是否具备可靠地生产无菌产品的基本能力,是非常有价值的,因此,无菌生产中培养基灌装 (工艺模拟试验)是:
◆工艺验证中关于产品无菌保证的最重要的部分;
◆是对于无菌生产工艺的检查中必须要考虑的点;
这一点,在众多的相关法规中,也有所体现:
◆EU Guidelines to Good Manufacturing Practice,Annex I 约半页纸长的文字说明了原则要求
◆FDA Guidance for Industry: Sterile DrugProducts Produced by Aseptic Processing (2004): 详细的要求,7 页。
◆ISO 13408-1 Aseptic processing of healthcare products, 1998 (draft of revised version from 2006 available) 详细要求, 5 页。
◆USP <1116>Microbiological Evaluation ofClean Rooms and other Controlled Environments 短的部分说明了原则要求 ,参照 FDA Aseptic Guide,(Ph.Eur. 5.1.1 中只有一句话)。
◆PIC Recommendation on the Validation ofAseptic Processes(详细要求, 7页, 对不同剂型有专门的说明,但其接受标准不再有效,但其接受标准不再有效)
◆Guide to Inspections of sterile Drugsubstance Manufacturer, FDA 1994 最佳操作规范:
◆PDA Technical Report No. 28, ProcessSimulation Testing for Sterile Bulk Pharmaceutical Chemicals, RevisedSupplement 2006 (非常详细的建议, 对于BPCs有专门的解决方案)。
◆PDA Technical Report No.22 1996,Process Simulation Testing for Aseptically Filled Products ( 非常详细, 重原理不重具体要求)。
如何确保无菌制造产品的无菌性?通过什么来证实这个过程的有效性?又如何做好培养基的灌装,确保它给出了不切实际的错误讯息?

我们都知道,无菌制造产品的无菌保证是基于以下各点的联合作用:
A.设施及制造工艺的设计
B.适当的设备 / 设备的灭菌
C.生产过程控制
E.验证
F.原料的生物负荷
G.人员培训及实际操作
H.测量系统,包括环境及人员的监控
这些要素能够有效地共同运作的能力, 是通过工艺模拟试验即培养基灌装来证实的,但是: 这些研究的价值在于,它只是实际生产过程的真实表现,因此工艺模拟必须尽量与实际生产过程参数一样。另外:培养基灌装甚至比最差情况挑战还要严格,因为几乎在所有情况下,微生物在培养基中的增殖要比在实际产品中更容易。
总体上来说,要做好培养基的灌装研究,需要关注以下16要点:
1.培养基灌装研究所包含的操作:
A.模拟必须包括产品成为无菌状态后的所有应用的无菌生产工艺步骤 (如转运, 灌装, 装载/卸载, 冻干, 加塞, 轧盖)
B.模拟必须包括所有的无菌处理 (如灌装线的设置, 无菌连接, 人员的介入操作)
C.培养基灌装研究不包括非无菌混合操作或产品的除菌工艺 (如无菌过滤)
D.培养基的制备和灭菌可以与产品的制备/除菌工艺采用不同的方式
2:实验的频率和数量 (每条灌装线的最小数量):
A.对于新的产品/设备/设施的首次验证:三个连续的循环;常规的每半年的再验证:一个培养基灌装循环,以证明状态是受控的!
B.再验证(对初始验证的重复)的原因: 在没有确切原因的情况下超出行动限度, 无菌工艺及/或设备的重大变化, 最终产品的无菌试验显示产品污染,长时间的停产。
3.产品/容器匹配的矩阵解决方案一条灌装线生产多个产品时,根据下列因素可被划分为不同的表型组:
A.灌装工艺
B.不同的容器密封方式
C.由此选出两个或更多个在下列方面能涵盖所有其它相关产品的产品:
D.容器的大小、开放或密封的设计
E.灌装线的速度和介入
F.涉及的操作人员数量
G.冻干, 贮存容器的形式
这些“矩阵产品” 都要包含在首次验证和再验证中。
4.培养基灌装实验采用的批量:
H.对于大多数传统的灌装工艺,5.000 到 10.000 单位就足够了
I.对于高速灌装线可能需要更多的单位
J.对于生产批量小于 5.000 的产品,培养基灌装的单位数应该至少等于日常生产的最大批量
5.培养基灌装过程中的注意事项:模拟灌装必须充分,要包括一定数量的典型介入和非典型的介入行为,数量要有代表性
A.必须包括停机和最大放置时间
B.必须包括更衣和倒班——如果这是正常生产的一部分
6.培养基的选择:
A.适宜促进宽范围的微生物生长,如大豆酪蛋白消化培养基(胰蛋白酶 大豆肉汤,TSB)
B.干粉工艺:具备与干粉产品流动性能相似的无菌TSB干粉或无菌安慰剂粉末(乳糖,甘露醇…)
C.培养基应该支持需氧菌生长,也支持厌氧菌的生长(皮肤生长的菌)
D.对于会形成严格厌氧环境的工艺:硫乙醇酸盐培养基(FTM) 能够支持真正的厌氧菌的生长(如果在环境监测样品或无菌试验中检出厌氧菌这样做也是必需的)
7.培养基的促生长试验:
A.必须用药典要求的标准微生物及工厂特定微生物(分离自环境监测及无菌试验)来进行
B.至少在培养期结束时应该进行。
C.挑战水平必须 < 100 CFU/单位。
8.灌装体积:选择的体积要使培养基能适当地接触容器内表面,并且当翻转或旋转时能接触到封口处的内表面。
A.25%至40%的顶空能确保获得足够的氧。
B.对于厌氧灌装: 用惰性气体代替氧气,并使之完全充满容器。
9.灌装单位的培养:
A.通常: 所有在工艺模拟中生产的培养基必须进行培养。
B.被排除在外未进行培养的单位,必须清楚地说明排除的合理性。
C.对于因容器破损而丢弃的单位,要求同日常生产一样。
D.完整的单位必须被培养,包括那些存在外观缺陷的单位。

10.培养条件:
A.足够的培养时间,以确保那些脆弱的或受损的微生物也能得到恢复并增殖(不少于14天)。
B.培养期间温度不超出 20-35℃的范围
C.如果用两个温度培养,从较低的温度开始,中间要观察结果
11.冻干法的模拟:
A.严格地用培养基模拟冻干工艺显然有难度(如循环可能持续几天)
B.应该首先识别有污染风险的活动,并加以模拟(如未完全密封小瓶的转运,冻干机的装载……)
C.冻干循环的模拟,应该采用一次或多次的部分真空
D.小瓶必须不被冷冻
E.注意确保培养基的需氧状态。
12.与人员相关的考虑:
A.在进行培养基灌装时要出现最大的人员数量。
B.所有受权进入无菌操作间的人员(包括技术人员和维护人员)必须至少每年参加一次培养基灌装。
C.进行有代表性数目、类型及复杂性的正常日常介入。
D.还要模拟非常规或非典型性介入/事件(维护,停机,设备调整)。
E.必须考虑操作人员的疲劳状态(如夜班)。
F.管理人员要评估每个操作人员对于书面操作程序的符合性(如录像资料)。
13.单位的检查:
A.目检是否有生长
B.单位的处理,要确保能检出在容器处或封口表面处的污染
C.要由经过培训,并且有资格能够发现微生物生长迹象的人员进行
D.在两个温度下培养时必须进行中间判读
E.可疑单位立即交给质量控制的微生物人员
14.环境监测:
A.进行总的悬浮粒子数及微生物的监测
B.监测必须覆盖所有的无菌工艺步骤,包括设置过程及设置人员
C.取样点,测试频率及样品数量应该与常规生产相同或更多以证实日常环境状况
15.所有剂型及所有无菌工艺的研究方案的总的要求
A.工艺模拟试验应该尽可能接近地模仿日常生产过程 ( 包括最差情况)
B.公司内对于培养基灌装中所要模拟的条件和活动的基本原则应有详细的说明
C.培养基灌装不能用作出现不必要的污染风险行为的理由。
16.接受标准与试验结果的判断:目标是零污染,任何污染都是客观事实,应进行调查.警报/行动水平如下:
A.当灌装少于 5000 单位时,不得检出污染单位,如果存在一个污染单位(行动水平),则需要启动调查,并进行再验证。
B.当灌装数量为5.000至10.000或更多单位时: 一个单位被污染 (警报水平)则需要启动调查,并考虑是否需要重复培养,如果存在两个单位被污染 (行动水平),需要启动调查,并进行再验证,污染单位必须与培养基灌装期间采取的模拟行为和其发生时间是相关联的。
C.必须有一个详细的书面程序,规定出现培养基灌装超出警报/行动水平时的处理程序,这里存在着大量的调查工作及文件记录。

【免责声明】 文章为转载,版权归原作者所有。如涉及作品版权问题,请与我们联系,我们将删除内容或协商版权问题!
原标题:《如何做好培养基的灌装16步。》











